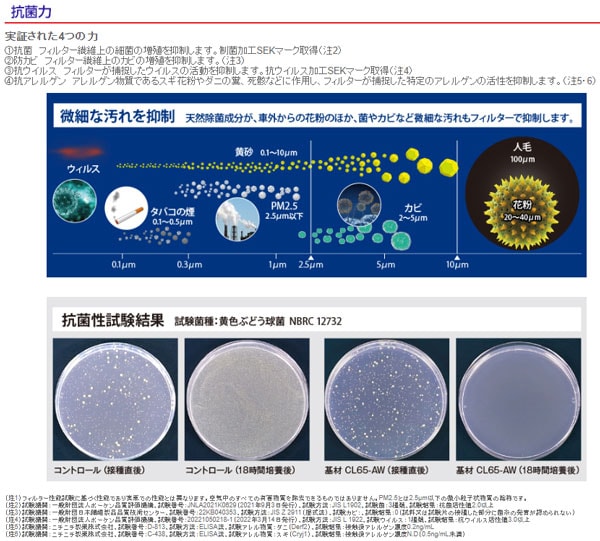

7/3
時点_ポイント最大11倍
PMC 活性炭入り脱臭タイプ(SKEマーク認証) エアコンフィルター ホンダ シビック Type R
販売価格
4,562
円 (税込)
送料込み
- 出荷目安:
- 取寄品:3~7営業日程で発送(土日祝除く)
たまるdポイント(通常) 41
+キャンペーンポイント(期間・用途限定) 最大10倍
※たまるdポイントはポイント支払を除く商品代金(税抜)の1%です。
※表示倍率は各キャンペーンの適用条件を全て満たした場合の最大倍率です。
各キャンペーンの適用状況によっては、ポイントの進呈数・付与倍率が最大倍率より少なくなる場合がございます。
dカードでお支払ならポイント3倍
各キャンペーンの適用状況によっては、ポイントの進呈数・付与倍率が最大倍率より少なくなる場合がございます。
- 商品情報
- レビュー

入数:1個
Cタイプの性能そのままに、SEKマーク認証を取得!
●集塵力
不織布が粗いホコリをがっちりブロック。
更に静電不織布(エレクトレット)が静電気の力で細かいホコリまで逃がさずキャッチ。
PM2.5など微小粒子状物質も高い効率で捕捉します。
●脱臭力
PMC社比最大の200g/m2の活性炭を独自のバインディング技術で粒状配置。
強力活性炭がタバコや排ガス、ペット臭などイヤな臭いを強力に除去します。
●安定風量
通気性と脱臭力・集塵効率を最適化したトータルバランスに優れた濾材設計。
余裕の通気性を確保した超高性能濾材で長時間にわたり安定した風量を維持します。
●抗菌力
(1)抗菌:フィルター繊維上の細菌の増殖を抑制します。制菌加工SEKマーク取得
(2)防カビ:フィルター繊維上のカビの増殖を抑制します。
(3)抗ウィルス:フィルターが捕捉したウイルスの活動を抑制します。抗ウイルス加工SEKマーク取得
(4)防アレルゲン:アレルゲン物質であるスギ花粉やダニの糞、死骸などに作用し、フィルターが捕捉した特定のアレルゲンの活性を抑制します。
■適合車種
ホンダ
シビック Type R FD2 2007年04月~2010年08月 全車標準設定
シビック Type R FD3 2005年09月~2010年12月 全車標準設定
シビック Type R FK2 2015年12月~2016年06月 全車標準設定
商品の詳細な情報はメーカーサイトをご確認ください。
商品画像にはカタログの代表画像を使用しております。
[画像内の品番・形状・サイズ・カラー・個数・容量・その他の仕様]が実物と異なる場合がございますので
商品名や説明文に記載の内容をよくご確認の上、ご購入いただきますようお願い申し上げます。
こちらは原則メーカーからのお取り寄せ商品となります。
メーカーからのお取り寄せ商品は、在庫切れや商品手配後に長期欠品・廃番が判明することもございます。
ご注文をいただいた時点では、商品の確保までお約束するものではございません。
また、商品の手配が行えないことが判明してから商品ページに反映されるまで、営業日・営業時間の都合により数日ほどお時間をいただく場合がございます。
当店ではこの商品の適合確認は行っておりません。
車種、年式、型式、グレードなどをよくお確かめの上ご注文ください。
また、サイズの表記があるものは形状等も併せてご確認いただくようお願いいたします。
商品の詳細情報についてはあらかじめご自身にてメーカーサイトをご確認いただきますようお願いいたします。
ご購入後の誤注文や商品不適合などでの返品・交換は致しかねますのであらかじめご了承・ご注意のうえご購入お願いいたします。
■品番
PC-510S
■関連事項
パシフィック工業 ぴーえむしー キャビンフィルター キャビンフィルタ エアコンフィルタ エアコンクリーンフィルター エアコンクリーンフィルタ クリーンフィルター クリーンフィルタ カーエアコン カーエアコンフィルター カーエアコンフィルタ エアコン キャビン フィルター フィルタ ダッシュボード フィルター交換 フィルタ交換 交換 集塵 花粉 脱臭 抗菌 防カビ 抗アレルゲン 抗ウィルス 静電不織布 エレクトレット
■メーカー情報
パシフィック工業 ぴーえむしー
■適合情報
タイプアール タイプR 本田 HONDA 本田技研工業
■その他
automobile motorcar オートモービル モーターカー カー 車 自動車 車両
■JAN
4977787051081










